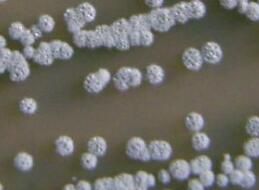
圓突起鏈黴菌

基本信息
中文學名圓突起鏈黴菌
拉丁學名Streptomycestorulosus
參考文獻Appl.Microbiol.22:190-193,1971.
形態特徵
孢子絲3-5圈圈卷。孢子表面結構特殊,為介於疣和刺之間的圓丘狀突起。孢子堆灰色。
性狀特徵
蔗糖硝酸鹽瓊脂上生長極好。產生類黑色素和H2S。從未表現吸水現象。利用D-葡萄糖、L-阿拉伯糖、D-木糖、D-果糖、蔗糖、L-鼠李糖、棉子糖、肌醇、D-甘露醇;不利用水楊苷。全細胞水解物含LL-二氨基庚二酸;還有甘露糖和阿拉伯糖。抑制枯草桿菌、藤黃八疊球菌、大腸桿菌、拉曼毛霉;對巴氏酵母作用弱;不抑制白色假絲酵母。
形態描述
孢子絲3-5圈圈卷。孢子表面結構特殊,為介於疣和刺之間的圓丘狀突起。
討論
代表菌株:S-124=F-57=NRRLB-3889。
圓突起鏈黴菌
圓突起鏈黴菌放線菌(六)
| 放線菌因菌落呈放線狀而的得名。它是一個原核生物類群,在自然界中分布很廣,主要以孢子繁殖,其次是斷裂生殖。放線菌在自然界分布廣泛,主要以孢子或菌絲狀態存在於土壤、空氣和水中,尤其是含水量低、有機物豐富、呈中性或微鹼性的土壤中數量最多。放線菌只是形態上的分類,不是生物學分類的一個名詞。有些細菌和真菌都可以劃歸到放線菌。土壤特有的泥腥味,主要是放線菌的代謝產物所致。 |

